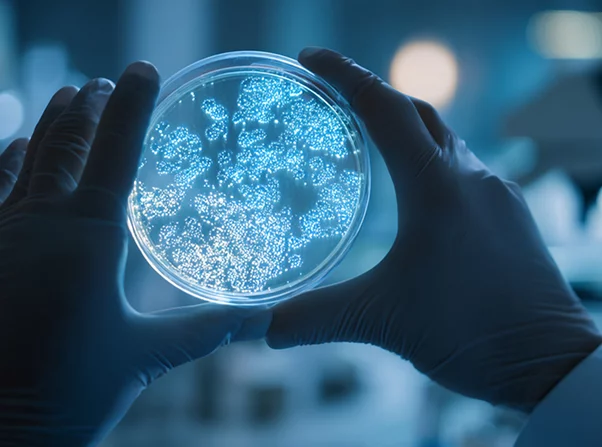

Banque du Liban’s new circulars aim to curb cash use, strengthen anti-money-laundering controls, and improve Lebanon’s chances of exiting the FATF grey list.
The Beiruter
-

The Beiruter
-
The Beiruter
-
-
-
-
-
-
-
-
-
-
-
-
-
-
-
-
-
-
-
-
-
-
-
-
-
-
-
-
-
-
-
-
-
-
-
-
-
-
-
-
-
-
-
-
-
-
-
After 18 years, student elections return to the Lebanese University
The planned return of student elections to the Lebanese University after 18 years marks a rare reopening of democratic life on campus, raising questions about political influence, youth representation, and whether long-promised education reforms can finally move from rhetoric to reality.
January 21, 2026 -

-
-
-
-
-
-
-
-
-
-
-
-
-
-
-
The closing chapter of the Ministry of the Displaced?
Lebanon plans to close the Ministry of the Displaced after more than three decades, once remaining compensation claims are settled and legal procedures completed. Minister Kamal Shehadeh says unresolved files and funding shortages continue to delay the process.
January 17, 2026 -

-
-
-
-
-
-
-
-
-
-
-
-
-
-
-
-
-
-
-
-
-
-
-
-
-
-
-
-
-
-
-
-
-
-
-
-
-
-
-
-
-
-
-
-
-
-
-
-
-
-
-
-
-
-
-
-
-
-
-
-
-
-
-
-
-
-
-
-
-
-
-
-
-
-
-
-
-
-
-
-
-
-
-
-
-
-
-
-
-
-
-
-
-
-
-
-
-
-
-
-
-
-
-
-
-
-
-
-
-
-
-
-
-
-
-
-
-
-
-
-
-
-
-
-
-
-
-
-
-
-
-
-
-
-
-
-
-
-
-
-
-
-
-
-
-
-
-
-
-
-
-
-
-
-
-
-
-
-
-
-
-
-
-
-
-
-
-
-
-
-
-
-
-
-
-
-
-
-
-
-
-
-
-
-
-
-
-
-
-
-
-
-
-
-
-
-
-
-
-
-
-
-
-
-
-
-
-
-
-
-
-
-
-
-
-
-
-
-
-
-
-
-
-
-
-
-
-
-
-
-
-
-
-
-
-
-
-
-
-
-
-
-
-
-
-
-
-
-
-
-
-
-
-
-
-
-
-
-
-
-
-
-
-
-
-
-
-
-
-
-
-
-
-
-
-
-
-
-
-
-
-
-
-
-
-
-
-
-
-
-
-
Arafat’s nephew returns, eyeing a place in Gaza’s post-war future
Nasser al-Qudwa, a longtime Fatah figure and critic of Mahmoud Abbas, has returned from exile to the West Bank amid post-war Gaza planning, positioning himself for a potential leadership role in the strip's future governance.
October 16, 2025 -

-
-
-
-
-
-
-
-
-
-
-
-
-
-
-
-
-
-
-
-
LAF commander seeks to enhance cooperation and support to the Lebanese army in Qatar
Lebanese Armed Forces Commander General Rodolphe Haykal’s visit to Qatar aims to strengthen bilateral ties and secure vital support for Lebanon’s military amid ongoing regional and domestic challenges.
October 11, 2025 -

-
-
-
-
-
-
-
-
-
-
-
-
-
-
-
-
-
-
Bitcoin’s wild ride: how the world’s first crypto keeps breaking and making records
Bitcoin has surged to a new all-time high above $125,000 amid economic uncertainty, rising ETF demand, and a weaker dollar, fueling both investor enthusiasm and ongoing concerns over its notorious volatility.
October 07, 2025 -

-
-
-
-
-
-
-
-
EU floats ‘reparations loan’ for Ukraine, tied to frozen russian assets
The European Union is advancing a groundbreaking plan to provide Ukraine with up to €140 billion in loans backed by profits from frozen Russian assets, aiming to hold Russia financially accountable for war damages while navigating complex legal and political challenges within the bloc.
October 04, 2025 -

-
-
-
-
-
-
-
-
Washington pledges $230M to lebanese security forces amid hezbollah tensions
The United States has approved $230 million in aid to Lebanon's security forces to strengthen state institutions and curb Hezbollah’s influence, a move welcomed by some regional allies but met with cautious responses in Europe due to its political implications.
October 03, 2025 -

-
-
-
-
-
-
Lebanese nationals detained aboard Gaza Global Sumud Flotilla
Lebanese nationals Lina Al-Tabbal and Mohammad Al-Qadri were detained by Israeli forces during the interception of the “Global Sumud Flotilla” carrying humanitarian aid to Gaza, as families and rights groups await clarity on the participants’ fate.
October 02, 2025 -

-
-
-
-
-
-
-
-
-
-
-
-
IMF–Lebanon: between reform promises and the long road to a final agreement
Lebanon’s negotiations with the IMF continue amid progress on reforms, but a final rescue deal remains elusive as banking, tax, and fiscal measures are still pending, leaving the country’s economic future uncertain.
September 27, 2025 -

-
-
-
-
Lebanon’s 2026 budget approved: no salary adjustments
Lebanon’s Cabinet has approved the 2026 budget, avoiding public sector salary hikes and new general taxes, but a controversial 3% import levy sparks fear of rising prices and inflation, raising concerns for households and businesses.
September 26, 2025 -

-
-
-
-
-
-
-
-
-
-
The race against time: Lebanon’s expatriate vote hangs in the balance
The debate over allowing Lebanese expatriates to vote from abroad highlights the country’s political deadlock, as hundreds of thousands of citizens face logistical hurdles, legislative delays, and uncertainty over their ability to participate in upcoming elections.
September 23, 2025 -

-
-
-
-
-
-
-
-
-
-
-
-
-
-
-
-
-
-
-
-
-
-
-
-
-
Lebanon’s deepening water crisis
Lebanon faces a severe national water crisis, worsened by climate change and decades of government neglect and corruption. In response, the energy ministry has launched an emergency plan that includes infrastructure repairs, public awareness campaigns, and a call for civic cooperation to conserve water.
September 03, 2025 -

-

.webp)
.webp)

.webp)
.webp)

-2.webp)
.webp)
.webp)





